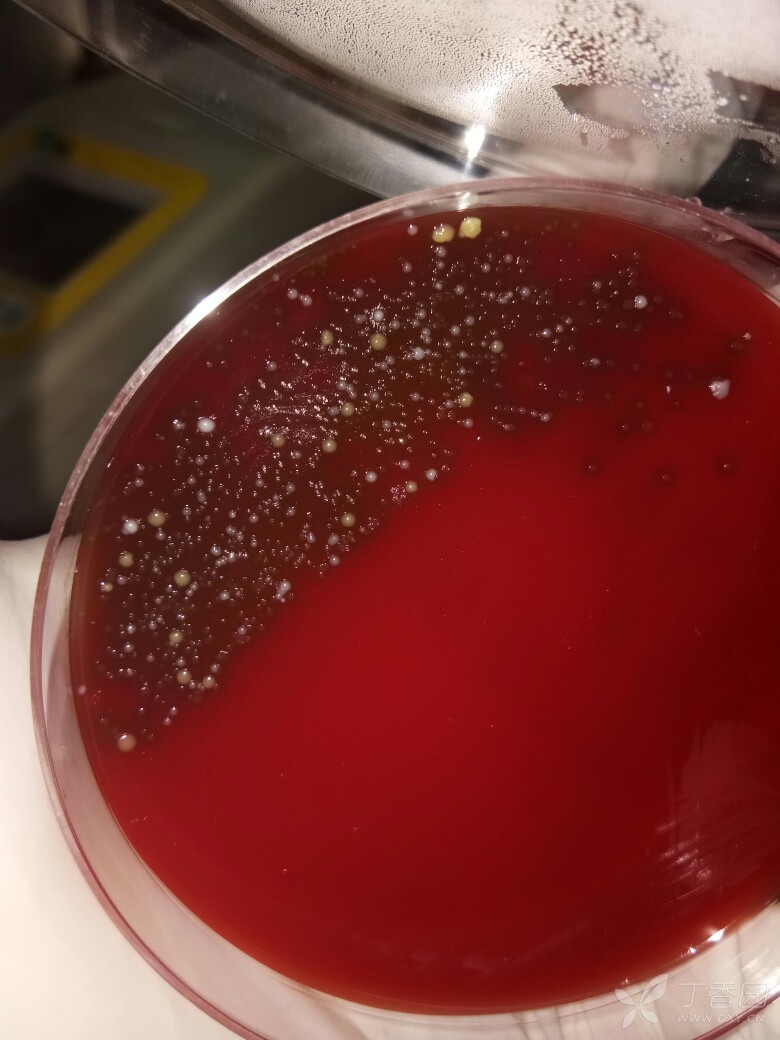
痰液培养

红色痰

吐血痰
图片尺寸300x220
一文讲清不同颜色的痰提示什么病菌感染欢迎收藏
图片尺寸1079x689
痰是黄的,带点血丝,无其症状,没发烧无咳
图片尺寸375x500
血液营养不足,可引起肿瘤溃疡,坏死,病人咳嗽时,坏死组织会伴随痰咳
图片尺寸428x325
都具有危险性,比如鼻腔出血要注意鼻癌,咳血,痰中带血是咽喉癌的表现
图片尺寸341x191
第1天为鲜红血液和血块,之后5天量减少,偶尔咳一下为痰中带点血(痰,血
图片尺寸615x631
咳嗽有痰咳嗽出一坨一坨的黄痰
图片尺寸1080x607
咳嗽嗓子痒今天又咳出了黄痰
图片尺寸768x1024
红色痰液红色血丝痰液,多见于肺结核或支气管扩张,平时咽部有炎症,上
图片尺寸640x640
不懂常见8大心脏病早期症状让无数人错过最佳治疗期
图片尺寸627x432
【科普讲座】为什么要做痰液检查?
图片尺寸600x663
半夜咳嗽痰是半透明条状,持续半个月,吃药暂时缓解,一停药就继续咳
图片尺寸375x500
今日病例痰培养检出1例圣乔治诺卡菌下
图片尺寸1080x810
痰液培养
图片尺寸780x1040
支气管炎肺炎痰太多导致的排痰很关键
图片尺寸544x720
喉咙痰多还老是咳不干净中医教你排痰法止咳祛痰见效快
图片尺寸1080x717
求助猫一直吐怎么回事啊
图片尺寸1080x1440
咳痰是身体在排毒不同颜色的痰各暗示什么疾病黄痰灰痰绿痰
图片尺寸1200x1200
老人常说黄痰轻黑痰重吐了白痰要了命是什么意思
图片尺寸681x381
可根据痰的颜色,观察肺部健康
图片尺寸500x500